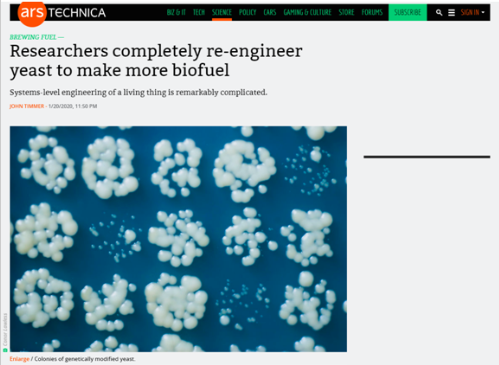

Source: School of Bioengineering
By Yao Lu, Li Xiang
Recently, together with Prof. Jens Nielsen from Chalmers University of Technology, Prof. Zhu Zhiwei from DUT School of Bioengineering, published their latest research results in the world’s top journal Nature Catalysis: “Multidimensional engineering of Saccharomyces cerevisiae for efficient synthesis of medium-chain fatty acids”, which marks that the research work of DUT in the field of biocatalytic transformation of medium-chain fatty acids has entered the forefront of the world.

Various media have reported this article. The famous technology review website Arstechnica.com published a comment article named "Brewing fuel—Researchers completely re-engineer yeast to make more biofuel", and triggered hundreds of comments by experts and scholars. This article has also been recommended by the Spotlight column of Trends in Biotechnology, an authoritative review journal in the field of bioengineering.

The abstract of the article:
Medium-chain fatty acids (MCFAs; C6–C12) are valuable molecules used for biofuel and oleochemical production; however, it is challenging to synthesize these fatty acids efficiently using microbial biocatalysts due to the cellular toxicity of MCFAs. In this study, both the endogenous fatty acid synthase (FAS) and an orthogonal bacterial type I FAS were engineered for MCFA production in the yeast Saccharomyces cerevisiae. To improve cellular tolerance to toxic MCFAs, the researchers performed directed evolution of the membrane transporter Tpo1 and strain adaptive laboratory evolution, which elevated the MCFA production by 1.3 ± 0.3- and 1.7 ± 0.2-fold, respectively. The researchers therefore further engineered the highly resistant strain to augment the metabolic flux towards MCFAs. This multidimensional engineering of the yeast at the single protein/enzyme level, the pathway level and the cellular level, combined with an optimized cultivation process, resulted in the production of >1 g l−1 extracellular MCFAs—a more than 250-fold improvement over the original strain.
Pleaser refer to the following websites - copy and go to browser to visit - to get more information about the article:
Zhu, Z. et al. Multidimensional engineering of Saccharomyces cerevisiae for efficient synthesis of medium-chain fatty acids. Nat Catal 3, 64-74, doi:10.1038/s41929-019-0409-1 (2020).
Nature chemistry community blog
Behind the paper: Efficient synthesis of valuable chemicals by engineered Baker’s yeasts.
Arstechnica.com
Brewing fuel—Researchers completely re-engineer yeast to make more biofuel
Treads in Biotechnology
Multidimensional Metabolic Engineering for Constructing Efficient Cell Factories
(20)30055-X
Editor: Li Xiang